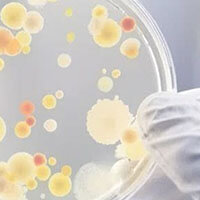
MICROBIOLOGIC DETECTION MICROBIOLOGIC DETECTION

Visualized Production processes
At LIYABEAUTY, we prioritize purchasing raw materials that are safe and environmentally friendly from all over the world. Our workers are highly skilled and operate high technology equipment in our new dust-free workshop for makeup products foaming, grinding, slitting, sewing, shaping, assembling, and packing efficiently.
Liya Beauty audited Certificate & Testing
Through persistent efforts, we have elevated our management practices to an advanced level in the makeup tools industry.
Our team has implemented innovative strategies and techniques, utilizing cutting-edge technology and industry-leading research to stay ahead of the competition.
Liya Beauty commitment to excellence and dedication to our customers has allowed us to become a leading company in the cosmetics industry.
Our success is a testament to the power of hard work and determination.

Digital Modeling

Water Content Testing

Tensile Testing
Microbiologic Detection

Density Detection

Color Comparison

Allergy Testing

Coating Fastness Testing

Tolerance Testing

Compaliance Certificate
Design and development
For ODM and OBM projects, our team can assist with every aspect of the design and development process. Whether you provide just a concept or a fully developed plan, we can creatively expand your product and tailor it to your specific needs.
Our team is skilled in Sketching, Material selection, Color matching, Shaping, Engineering design, and small batch verification. We work closely with you throughout the process to ensure every detail is perfect.
Trust us to bring your vision to life.
What corporate culture we have always advocated?
Our mission
We try to make everything people-oriented, to help our workers achieve self-fulfillment.
Our Value
INNOVATIVE
We always prioritize the latest design, creative ideas, and advanced concepts to ensure a successful market launch.
LOYAL
Every member of our workforce is loyal to their family, to their partner, as well as loyal to the customer and the company.
DILIGENT
With 100% diligence, our work is impeccable and our workforce has elevated significantly.
RESPONSIBLE
With duties, we perpetually carry out our purpose.
Our Vison
Become a role model for peer learning and emulation.
All successful people focus on simple small things as they insist on them.
I have always believed that learning from both successful and failed cases is essential for personal and professional growth. As a professional engineer and makeup designer specializing in makeup tools, I can attest to this statement’s validity.
Establishing Liya Beauty in 2012 was not an easy task, but through perseverance and dedication, we have grown into a successful makeup sponge and brush customization development factory. We take pride in serving leading beauty brands who wish to have their own private label and have over 1000 customers in OEM & ODM services. Our products have gained popularity in various regions, including North America, Europe, and East Asia.
Our team is vibrant, dynamic, and results-driven, with a passion for ethical and sustainable growth strategies. We are committed to being a global cooperative platform as a leading makeup tools producer. Through our experiences, we have learned that success is not an overnight accomplishment but a product of hard work, dedication, and learning from our past mistakes. We continue to strive for excellence and innovation in our products and services.
In conclusion, I am grateful for the lessons I have learned from both successful and failed cases. They have helped me become a better engineer and makeup designer, and I am proud to be a part of Liya Beauty’s success.
Our History
Since our establishment in 2012, we have been relentlessly working towards gaining recognition and appreciation from the world’s top customers. We are committed to enhancing our quality standards and management processes to cater to our present and future clients. Our unwavering dedication to excellence is what sets us apart from the rest.
FAQ
We are committed to offering premium service and guarantee to ensure that you have the best experience in makeup sponge and brush OEM, ODM, and OBM services.
You can find our common service information as follows.
Please do not hesitate to contact us if you need anything.

































